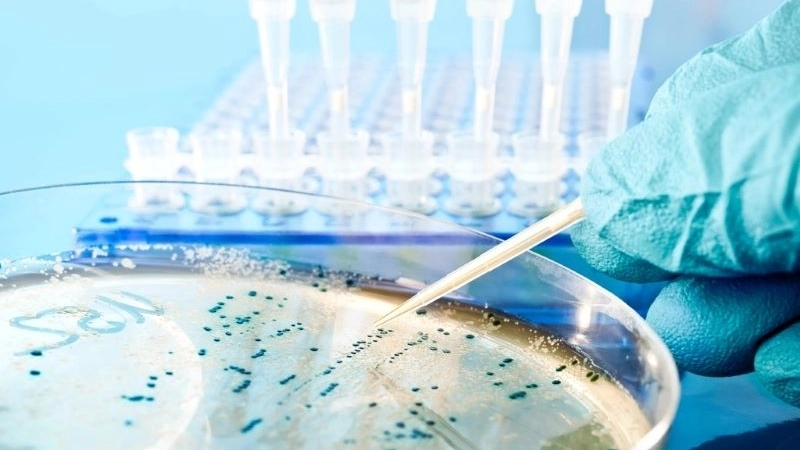

Công nghệ sinh học y tế là lĩnh vực phát triển nhanh và mang tính cách mạng trong y học hiện đại. Nhờ ứng dụng các kỹ thuật tiên tiến, công nghệ này giúp cải thiện phương pháp điều trị, chẩn đoán và phòng ngừa bệnh hiệu quả hơn, mở ra nhiều cơ hội mới cho ngành chăm sóc sức khỏe.
Định nghĩa và vai trò quan trọng trong chăm sóc sức khỏe
Công nghệ sinh học y tế là một lĩnh vực kết hợp giữa sinh học và công nghệ hiện đại để phát triển các giải pháp y học tiên tiến, hỗ trợ chẩn đoán, điều trị và phòng ngừa bệnh tật. Đây là ngành khoa học ứng dụng các kỹ thuật sinh học phân tử, di truyền học, công nghệ tế bào, và nhiều công nghệ khác nhằm tạo ra sản phẩm y tế như thuốc, vắc-xin, phương pháp xét nghiệm và liệu pháp gen.
Với sự phát triển nhanh chóng của khoa học và công nghệ, công nghệ sinh học y tế ngày càng khẳng định vai trò quan trọng trong việc nâng cao chất lượng cuộc sống, kéo dài tuổi thọ và giảm thiểu chi phí y tế. Nó không chỉ giúp phát hiện bệnh nhanh chóng, chính xác mà còn mở ra nhiều hướng điều trị mới cho những căn bệnh khó chữa như ung thư, các bệnh di truyền, và nhiều bệnh mãn tính khác.
Một trong những lợi ích nổi bật của công nghệ sinh học y tế là khả năng cá nhân hóa điều trị. Thông qua phân tích gen và các chỉ số sinh học, các bác sĩ có thể lựa chọn phương pháp điều trị phù hợp với từng bệnh nhân, nâng cao hiệu quả và giảm tác dụng phụ. Đây chính là bước tiến lớn trong y học hiện đại, góp phần thay đổi cách chăm sóc sức khỏe toàn cầu.
Click để xem thêm: Công nghệ dược phẩm hiện đại thay đổi ngành y ra sao?
Các ứng dụng nổi bật của công nghệ sinh học y tế trong chẩn đoán và điều trị bệnh
Công nghệ sinh học y tế đã tạo ra nhiều bước đột phá trong lĩnh vực chẩn đoán bệnh, giúp phát hiện sớm và chính xác các căn bệnh nguy hiểm. Các kỹ thuật như PCR (phản ứng chuỗi polymerase), xét nghiệm gen, xét nghiệm mô học phân tử, và công nghệ cảm biến sinh học được ứng dụng rộng rãi tại các phòng thí nghiệm y tế hiện đại. Nhờ vậy, nhiều bệnh lý như viêm gan, HIV, ung thư, và các bệnh di truyền được phát hiện ở giai đoạn đầu, từ đó nâng cao khả năng chữa trị thành công.
Ngoài ra, công nghệ sinh học y tế còn mang đến các phương pháp điều trị tiên tiến như liệu pháp gen, tế bào gốc, và thuốc sinh học (biologics). Liệu pháp gen giúp sửa chữa hoặc thay thế những đoạn gen bị lỗi, mở ra cơ hội chữa trị các bệnh di truyền mà trước đây gần như không thể điều trị dứt điểm. Tế bào gốc được sử dụng để tái tạo mô và cơ quan bị tổn thương, giúp hồi phục chức năng một cách tự nhiên hơn.
Thuốc sinh học, được tạo ra từ các sản phẩm sinh học như protein, kháng thể đơn dòng, đã trở thành “vũ khí” mạnh mẽ trong cuộc chiến chống lại nhiều loại bệnh như ung thư, viêm khớp, và các bệnh tự miễn. So với thuốc tổng hợp truyền thống, thuốc sinh học thường có độ đặc hiệu cao hơn và ít tác dụng phụ hơn.

Click để xem thêm: Công nghệ hồ sơ y tế số thay đổi ngành y tế như thế nào?
Xu hướng phát triển và thách thức của công nghệ sinh học y tế trong tương lai
Công nghệ sinh học y tế đang trên đà phát triển mạnh mẽ với sự hỗ trợ của trí tuệ nhân tạo, công nghệ big data và kỹ thuật nano. Những công nghệ này hứa hẹn sẽ giúp phân tích dữ liệu sinh học lớn, tìm ra các mối liên hệ phức tạp trong quá trình sinh bệnh và từ đó phát triển những phương pháp điều trị cá thể hóa hơn, hiệu quả hơn.
Một xu hướng quan trọng khác là phát triển các thiết bị y tế thông minh và các công nghệ xét nghiệm nhanh tại chỗ, giúp người dùng có thể tự theo dõi sức khỏe một cách dễ dàng mà không cần đến bệnh viện. Điều này rất phù hợp với cuộc sống hiện đại khi nhu cầu chăm sóc sức khỏe chủ động ngày càng tăng cao.
Tuy nhiên, công nghệ sinh học y tế cũng đối mặt với nhiều thách thức lớn. Đầu tiên là vấn đề đạo đức và pháp lý liên quan đến việc ứng dụng công nghệ gen và liệu pháp tế bào. Việc sử dụng công nghệ sinh học cần được kiểm soát chặt chẽ để tránh các nguy cơ tiềm ẩn như biến đổi gen ngoài ý muốn hoặc lạm dụng công nghệ cho mục đích không đúng.
Bên cạnh đó, chi phí nghiên cứu và phát triển sản phẩm công nghệ sinh học y tế thường rất cao, đòi hỏi sự đầu tư lớn từ cả nhà nước và doanh nghiệp. Việc chuyển giao công nghệ và đào tạo nguồn nhân lực chất lượng cao cũng là vấn đề cần được quan tâm để ứng dụng công nghệ một cách hiệu quả và bền vững.

Công nghệ sinh học y tế không chỉ là xu hướng mà còn là giải pháp then chốt giúp nâng cao chất lượng điều trị và chăm sóc sức khỏe. Việc tiếp tục đầu tư và phát triển công nghệ này sẽ góp phần xây dựng nền y tế hiện đại, mang lại lợi ích thiết thực cho người bệnh và cộng đồng.
Click để xem thêm: Tại sao công nghệ AI chẩn đoán ngày càng được ứng dụng rộng rãi?